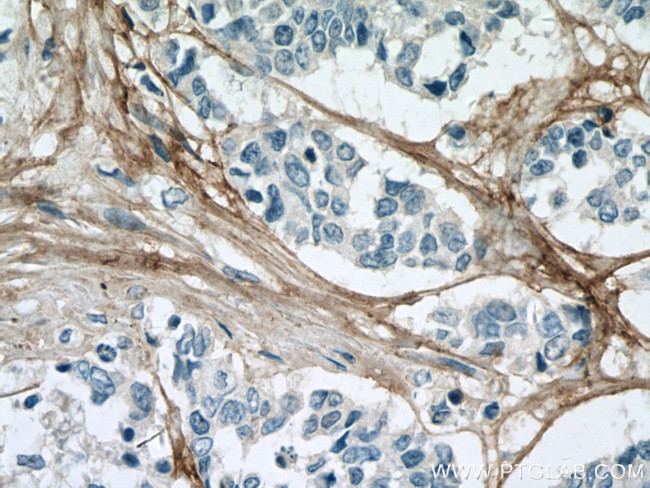
Collagen Type VI Antibody in Immunohistochemistry (Paraffin) (IHC (P))

Search
Proteintech
Collagen Type VI Monoclonal Antibody (3H10B1)
{{$productOrderCtrl.translations['antibody.pdp.commerceCard.promotion.promotions']}}
{{$productOrderCtrl.translations['antibody.pdp.commerceCard.promotion.viewpromo']}}
{{$productOrderCtrl.translations['antibody.pdp.commerceCard.promotion.promocode']}}: {{promo.promoCode}} {{promo.promoTitle}} {{promo.promoDescription}}. {{$productOrderCtrl.translations['antibody.pdp.commerceCard.promotion.learnmore']}}
产品信息
66824-1-IG
种属反应
宿主/亚型
分类
类型
克隆号
抗原
偶联物
形式
浓度
纯化类型
保存液
内含物
保存条件
运输条件
产品详细信息
Immunogen sequence: NVISCQGLA PSQGRPGLSL VKENYAELLE DAFLKNVTAQ ICIDKKCPDY TCPITFSSPA DITILLDGSA SVGSHNFDTT KRFAKRLAER FLTAGRTDPA HDVRVAVVQY SGTGQQRPER ASLQFLQNYT ALASAVDAMD FINDATDVND ALGYVTRFYR EASSGAAKKR LLLFSDGNSQ GATPAAIEKA VQEAQRAGIE IFVVVVGRQV NEPHIRVLVT GKTAEYDVAY GESHLFRVPS YQALLRGVFH QTVSRKVALG (770-1028 aa encoded by BC052575)
靶标信息
The extensive family of COL gene products (collagens) is composed of several chain types, including fibril-forming interstitial collagens (typesI, II, III and V) and basement membrane collagens (type IV), each type containing multiple isoforms. Collagens are fibrous, extracellular matrix proteins with high tensile strength and are the major components of connective tissue, such as tendons and cartilage. All collagens contain a triple helix domain and frequently show lateral self-association in order to form complex connective tissues. Several collagens also play a role in cell adhesion, important for maintaining normal tissue architecture and function.
仅用于科研。不用于诊断过程。未经明确授权不得转售。
篇参考文献 (0)
生物信息学
蛋白别名: alpha 1 (VI) chain (61 AA); Collagen alpha-1(VI) chain; collagen VI, alpha-1 polypeptide; collagen, type VI, alpha 1
基因别名: BTHLM1; COL6A1; OPLL; UCHMD1
UniProt ID: (Human) P12109
Entrez Gene ID: (Human) 1291